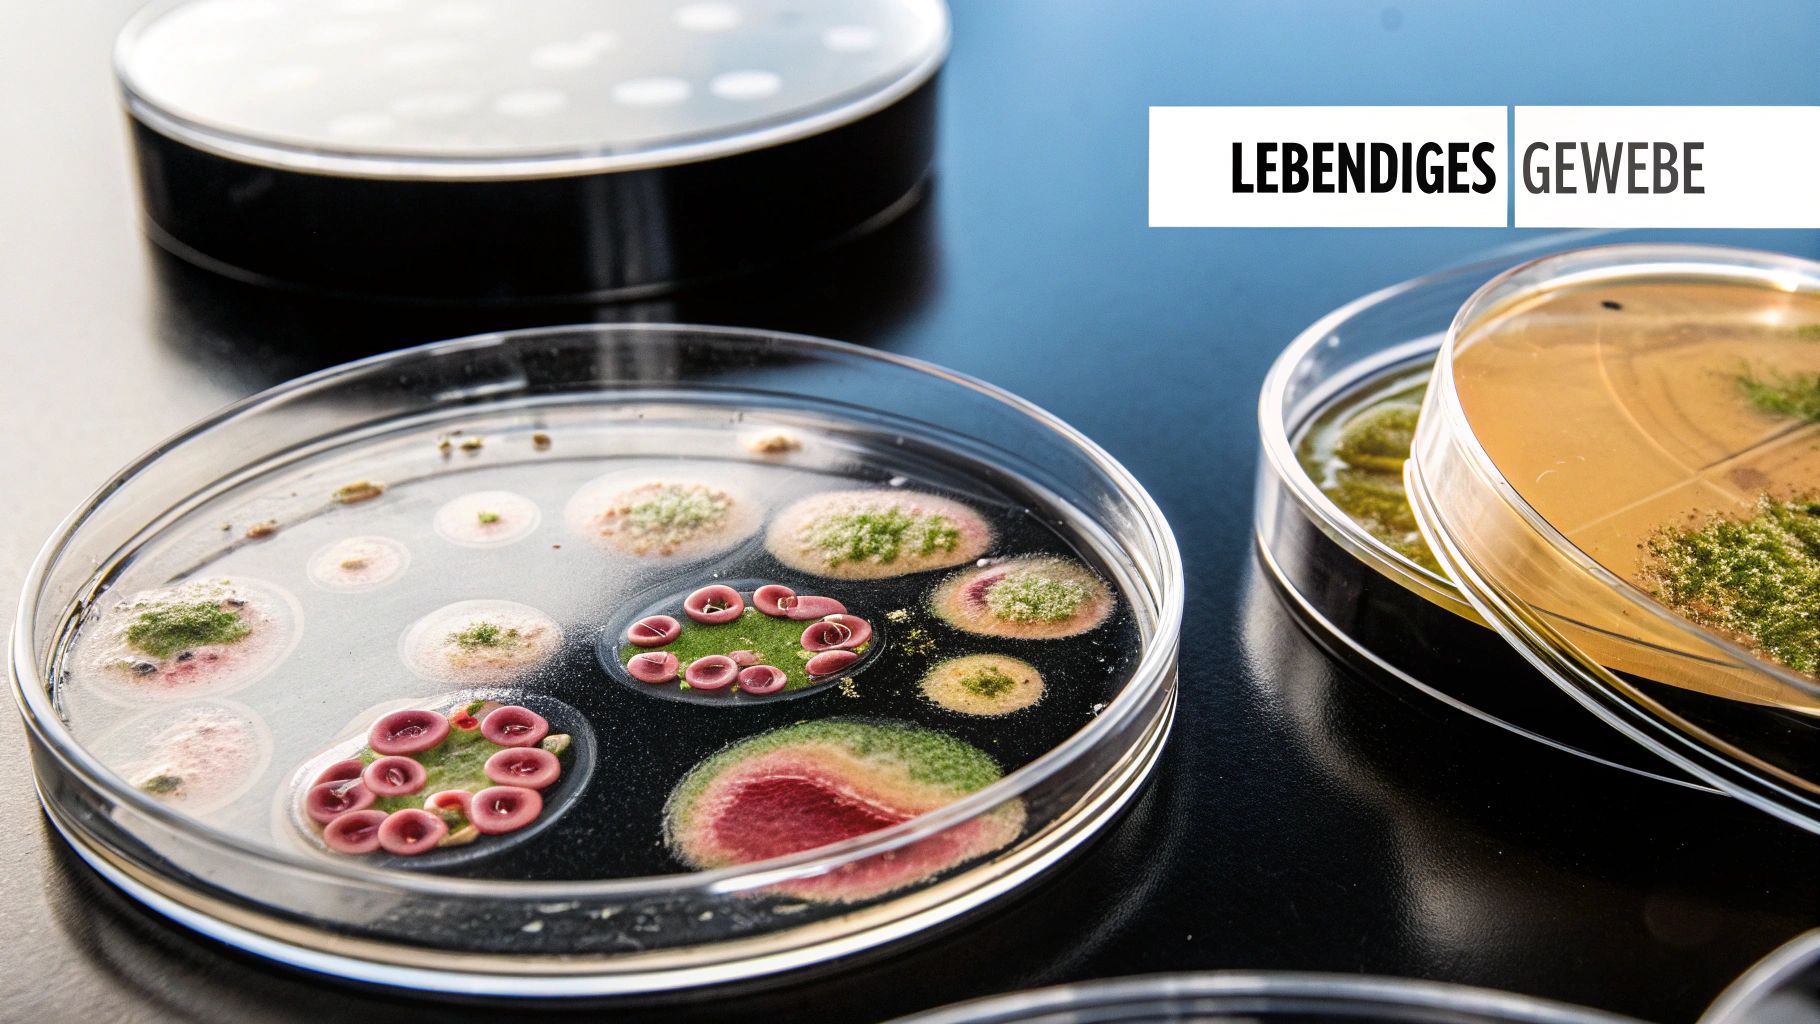

Was ist ein Knorpel? Wichtige Infos & Funktionen
Knorpel – man hört das Wort oft, aber was steckt eigentlich dahinter? Im Grunde ist es ein festes, aber gleichzeitig biegsames Bindegewebe, das an vielen Stellen in unserem Körper entscheidende Schutz- und Stützfunktionen übernimmt. Man kann es sich am besten als den Stoßdämpfer und gleichzeitig Formgeber des Körpers vorstellen. Er schmiert unsere Gelenke, schützt die empfindlichen Knochenenden und gibt Strukturen wie der Nase und den Ohren ihre einzigartige Form. Ohne Knorpel wäre eine reibungslose Bewegung, wie wir sie kennen, schlicht und einfach undenkbar.
Die zentrale Rolle von Knorpel in deinem Körper
Wenn wir an unser Skelett denken, kommen uns meistens zuerst die Knochen in den Sinn. Aber der Knorpel ist der stille Held im Hintergrund, der das reibungslose Zusammenspiel zwischen den Knochen überhaupt erst möglich macht. Anders als Knochen hat Knorpelgewebe keine eigenen Blutgefäße oder Nerven. Das macht ihn zwar unglaublich widerstandsfähig, führt aber auch dazu, dass er nur sehr langsam heilt, wenn er mal beschädigt ist.
Stell dir Knorpel am besten wie einen dichten, nassen Schwamm vor. Bei jeder Bewegung, zum Beispiel beim Gehen oder Laufen, wird dieser Schwamm komprimiert und gibt verbrauchte Flüssigkeit ab. Sobald der Druck nachlässt, saugt er sich sofort wieder mit nährstoffreicher Gelenkflüssigkeit voll. Dieser geniale Mechanismus ist für seine Ernährung und Gesundheit absolut entscheidend.
Mehr als nur ein Puffer
Knorpel ist weit mehr als nur ein passives Polster. Er ist ein dynamisches, lebendiges Gewebe, das sich permanent an die Belastungen anpasst, denen es ausgesetzt ist. Seine einzigartige Struktur verleiht ihm wirklich bemerkenswerte Eigenschaften:
- Druckfestigkeit: Er kann enormen Kräften standhalten, ohne sich dauerhaft zu verformen – denk nur mal an die Belastung in unseren Knien bei jedem Schritt.
- Elastizität: Nach einer Belastung kehrt er wieder in seine ursprüngliche Form zurück. Das ist unerlässlich für die Formgebung unserer Ohren und der Nase.
- Glatte Oberfläche: In den Gelenken sorgt er für eine fast reibungsfreie Gleitfläche, damit die Knochenenden mühelos aneinander vorbeibewegen können.
Obwohl Knorpel eng mit anderen Bindegeweben zusammenarbeitet, unterscheidet er sich fundamental von ihnen. In unserem weiterführenden Artikel kannst du übrigens mehr über den Unterschied zwischen Sehnen und Bändern lesen und verstehen, wie diese Strukturen im Bewegungsapparat zusammenspielen.
Knorpel ist ein faszinierendes Gewebe, das Stabilität und Flexibilität perfekt kombiniert. Seine Gesundheit ist die Grundlage für schmerzfreie Bewegung und die Integrität vieler Körperstrukturen.
In den folgenden Abschnitten tauchen wir noch tiefer in die Welt dieses außergewöhnlichen Materials ein. Du wirst erfahren, wie er aufgebaut ist, welche verschiedenen Arten es gibt und was du selbst tun kannst, um ihn zu schützen und zu stärken.
Wie Knorpel aufgebaut ist und sich ernährt
Um zu verstehen, warum Knorpel so besonders und gleichzeitig so empfindlich ist, müssen wir uns seinen Aufbau mal genauer ansehen. Stell dir ein extrem widerstandsfähiges, aber dennoch flexibles Netz vor – so ähnlich ist Knorpel auf mikroskopischer Ebene gestrickt. Im Grunde besteht er aus drei Hauptkomponenten.
Den Löwenanteil macht die sogenannte extrazelluläre Matrix aus. Sie ist das stabile Grundgerüst, das hauptsächlich aus Wasser besteht. Das ist auch der Grund für seine geniale Stoßdämpferfunktion. In diesem Wasser sind lange, zugfeste Kollagenfasern und spezielle Zuckereiweißmoleküle, die Proteoglykane, eingebettet. Diese Moleküle sind wahre Wassermagneten und verleihen dem Knorpel seine typisch pralle, elastische Konsistenz.
Die Baumeister des Knorpels
Inmitten dieser Matrix sitzen die eigentlichen Arbeiter des Gewebes: die Chondrozyten. Das sind tatsächlich die einzigen Zellen, die im Knorpel vorkommen. Ihre Aufgabe ist es, die Matrix unermüdlich zu erneuern und instand zu halten.
Dieser Job ist allerdings alles andere als einfach, denn Knorpel hat eine entscheidende Eigenart: Er ist avaskulär. Das bedeutet schlicht, dass er keine eigenen Blutgefäße besitzt. Einerseits macht ihn das extrem widerstandsfähig gegen Druck, andererseits stellt es die Chondrozyten bei der Nährstoffversorgung vor eine riesige Herausforderung.
Anders als Knochen, die von einem dichten Netz aus Blutgefäßen durchzogen sind, muss Knorpel seinen Lebensunterhalt auf einem völlig anderen Weg sichern. Dieser Mangel an direkter Blutzufuhr ist auch der Hauptgrund, warum Knorpelschäden so schlecht und langsam heilen.
Wenn du mehr über diesen fundamentalen Unterschied im Aufbau wissen möchtest, schau dir doch unseren Artikel über die Anatomie der menschlichen Knochen an.
Ernährung durch Bewegung
Wie also überlebt ein Gewebe ohne direkte Anbindung an den Blutkreislauf? Die Antwort liegt in einem genialen Mechanismus, den man oft als „Gelenkpumpe“ bezeichnet. Die Ernährung läuft über Diffusion aus der umliegenden Gelenkflüssigkeit, der Synovia.
Am besten kann man sich das mit einem Küchenschwamm vorstellen. Der Prozess funktioniert in zwei Phasen:
- Belastung: Wenn du ein Gelenk bewegst und der Knorpel dabei zusammengedrückt wird, presst er verbrauchte Flüssigkeit mitsamt Abfallprodukten heraus. Der Schwamm wird quasi ausgewrungen.
- Entlastung: Sobald der Druck nachlässt, dehnt sich der Knorpel wieder aus und saugt sich wie ein Schwamm mit frischer, nährstoffreicher Gelenkflüssigkeit voll.
Dieser ständige Wechsel aus Be- und Entlastung ist für den Knorpel absolut überlebenswichtig. Bewegung ist also nicht nur für die Muskeln gut, sondern buchstäblich die einzige Möglichkeit, den Knorpel gesund zu halten. Ohne regelmäßige Bewegung würde er im wahrsten Sinne des Wortes verhungern, was über kurz oder lang zu seinem Abbau führt.
Die drei Knorpeltypen und ihre Spezialaufgaben
Knorpel ist nicht gleich Knorpel. Man könnte meinen, es sei alles das gleiche gummiartige Gewebe, aber der menschliche Körper ist da viel cleverer. Im Laufe der Evolution hat er dieses Material perfektioniert und für ganz unterschiedliche Jobs drei spezialisierte Varianten entwickelt. Jeder Typ hat eine einzigartige Zusammensetzung und damit seine ganz eigenen Superkräfte.
Stell es dir wie bei gutem Werkzeug vor: Du würdest ja auch keinen Hammer nehmen, um eine Schraube einzudrehen. Genauso setzt der Körper für reibungsloses Gleiten in Gelenken, flexible Formgebung am Ohr oder extreme Stoßdämpfung in der Wirbelsäule jeweils den passenden Knorpeltyp ein. Diese geniale Spezialisierung ist der Schlüssel zu unserer Beweglichkeit und Stabilität.
Die folgende Infografik gibt dir einen super Überblick, wo die drei Haupttypen im Körper zu finden sind und was sie dort leisten.

Man sieht sofort, dass jeder Knorpeltyp strategisch genau dort platziert ist, wo seine besonderen Fähigkeiten am dringendsten gebraucht werden.
Hyaliner Knorpel: der glatte Allrounder
Der häufigste Knorpel in unserem Körper ist mit Abstand der hyaline Knorpel. Sein Name kommt vom griechischen Wort „hyalos“, was so viel wie „gläsern“ bedeutet. Und das trifft es ziemlich gut: Er sieht bläulich-weiß und leicht durchscheinend aus.
Seine Hauptaufgabe? Eine extrem glatte, widerstandsfähige Oberfläche zu schaffen, die Reibung auf ein absolutes Minimum reduziert. Er überzieht die Enden unserer Knochen in den Gelenken wie eine spiegelglatte Eisschicht. Dadurch können die Gelenkflächen fast widerstandslos aufeinander gleiten, während gleichzeitig Stöße abgefedert werden.
Hier findest du den hyalinen Knorpel hauptsächlich:
- Gelenkflächen: An Knien, Hüften, Schultern – im Grunde in allen beweglichen Gelenken.
- Rippen: Er schafft die elastische Verbindung zwischen Rippen und Brustbein.
- Atemwege: Er stabilisiert die Luftröhre und die Bronchien, damit sie immer offenbleiben.
- Nase: Ein großer Teil des Nasengerüsts besteht aus diesem Knorpeltyp.
Elastischer Knorpel: der flexible Formgeber
Wie der Name schon andeutet, ist die herausragende Eigenschaft des elastischen Knorpels seine unglaubliche Biegsamkeit. Er kann sich stark verformen, springt aber immer wieder in seine ursprüngliche Form zurück. Das liegt an einem dichten Netz aus elastischen Fasern, das ihm auch seine typisch gelbliche Farbe gibt.
Denk nur mal an deine Ohrmuschel: Du kannst sie biegen und knautschen, aber sie nimmt sofort wieder ihre alte Form an. Genau das ist die Magie des elastischen Knorpels.
Elastischer Knorpel kommt überall dort zum Einsatz, wo Strukturen gleichzeitig stabil und extrem flexibel sein müssen. Er gibt die Form vor, ohne die Beweglichkeit einzuschränken.
Seine wichtigsten Einsatzorte sind:
- Ohrmuschel: Verleiht dem äußeren Ohr seine charakteristische Form und Flexibilität.
- Kehldeckel (Epiglottis): Muss beim Schlucken blitzschnell die Luftröhre verschließen und braucht dafür maximale Beweglichkeit.
- Eustachi-Röhre: Teile der Ohrtrompete, die für den Druckausgleich im Ohr sorgt.
Faserknorpel: der robuste Stoßdämpfer
Der Faserknorpel ist das absolute Kraftpaket unter den Knorpeltypen – der zäheste und widerstandsfähigste von allen. Er ist eine clevere Mischung aus straffem Bindegewebe und klassischem Knorpel, vollgepackt mit dicken Bündeln aus Kollagenfasern. Das macht ihn extrem zug- und druckfest.
Seine Hauptfunktion ist klar definiert: gewaltige Kräfte abfedern und als Puffer dienen. Du findest ihn überall dort, wo es im Körper richtig zur Sache geht und hohe Druck- und Scherbelastungen auftreten.
Die bekanntesten Beispiele für Faserknorpel sind:
- Bandscheiben: Sie liegen als unermüdliche Stoßdämpfer zwischen den einzelnen Wirbeln.
- Menisken: Die halbmondförmigen Knorpelscheiben im Knie, die den Druck bei jedem Schritt verteilen.
- Schambeinfuge (Symphyse): Verbindet die beiden Hälften des Beckens an der Vorderseite bombenfest.
Vergleich der Knorpeltypen
Um die Unterschiede noch klarer zu machen, haben wir die drei Spezialisten in einer Tabelle gegenübergestellt. Diese Übersicht fasst die wichtigsten Merkmale, Funktionen und Vorkommen kompakt zusammen.
| Merkmal | Hyaliner Knorpel | Elastischer Knorpel | Faserknorpel |
|---|---|---|---|
| Zusammensetzung | Hoher Wassergehalt, feine Kollagen-II-Fasern, glasartige Matrix | Kollagen-II-Fasern plus ein dichtes Netz aus elastischen Fasern | Sehr viele dicke Kollagen-I-Faserbündel, wenig Matrix |
| Hauptfunktion | Reibungsarme Gelenkflächen, Stabilität | Hohe Elastizität, Formgebung, Flexibilität | Extreme Stoßdämpfung, Zug- und Druckfestigkeit |
| Typische Vorkommen | Gelenke, Rippen, Nase, Luftröhre | Ohrmuschel, Kehldeckel, Eustachi-Röhre | Bandscheiben, Menisken, Schambeinfuge |
Wie du siehst, hat jeder Knorpeltyp sein ganz eigenes Spezialgebiet. Diese durchdachte Aufgabenteilung ist ein perfektes Beispiel dafür, wie effizient und anpassungsfähig unser Körper aufgebaut ist.
Wenn der Knorpel nachgibt: Von Knorpelschaden bis Arthrose
So unglaublich widerstandsfähig unser Knorpelgewebe auch ist, unverwundbar ist es leider nicht. Seine besondere Struktur, die ganz ohne eigene Blutversorgung auskommen muss, macht es anfällig für Schäden – und die Heilung gestaltet sich oft extrem schwierig. Sobald die glatte, schützende Oberfläche aufgeraut wird oder sogar Risse bekommt, sprechen wir von einem Knorpelschaden.
Manchmal passiert es ganz plötzlich, durch eine unglückliche Bewegung beim Sport oder einen Unfall. Viel häufiger ist es jedoch ein schleichender Prozess, der sich über Jahre hinzieht. Chronische Überlastung durch Übergewicht, Fehlstellungen wie X- oder O-Beine oder einfach der ganz natürliche Verschleiß im Laufe des Lebens – all das setzt dem Knorpel stetig zu.
Von der Abnutzung zur Arthrose
Wenn der Knorpelabbau ein kritisches Maß erreicht und zu dauerhaften Veränderungen im Gelenk und Schmerzen führt, lautet die Diagnose vom Arzt oft: Arthrose. Man kann es sich ein bisschen wie eine Straße vorstellen, deren glatter Asphalt langsam bröckelig wird. Zuerst entstehen nur feine Risse, dann brechen ganze Stücke heraus, bis die Fahrt über die Straße holprig und schmerzhaft wird.
Arthrose ist weit mehr als eine simple Alterserscheinung – sie ist die häufigste Gelenkerkrankung weltweit. Dabei wird nicht nur der Knorpel dünner und rauer, sondern der gesamte Stoffwechsel des Gelenks gerät aus dem Gleichgewicht. Der Körper versucht zwar, den Schaden zu reparieren, doch diese Bemühungen führen oft zu knöchernen Anbauten am Gelenkrand (sogenannten Osteophyten), die die Beweglichkeit nur noch weiter einschränken.
Arthrose ist ein echter Teufelskreis: Der kaputte Knorpel reizt die Gelenkinnenhaut, was zu schmerzhaften Entzündungen und Schwellungen führt. Die Schmerzen verleiten zur Schonung, aber genau diese fehlende Bewegung verschlechtert die Nährstoffversorgung des Knorpels noch weiter.
Die ersten Anzeichen einer beginnenden Arthrose sind oft sehr subtil und werden leicht übersehen. Achte mal auf folgende Signale:
- Anlaufschmerz: Fühlen sich die Gelenke morgens oder nach langem Sitzen steif an und schmerzen die ersten Schritte?
- Belastungsschmerz: Treten die Schmerzen vor allem während oder nach körperlicher Anstrengung auf?
- Gelenksteifigkeit: Lässt die Beweglichkeit des Gelenks spürbar nach?
- Knirsch- und Reibegeräusche: Hörst du manchmal seltsame Geräusche aus dem Gelenk bei Bewegung?
Ein Blick auf die Zahlen macht klar, wie verbreitet das Problem ist. In Deutschland leidet bereits mehr als ein Viertel der Frauen und etwa 15 Prozent der Männer im Alter von 45 bis 64 Jahren an Arthrose. Und diese Zahlen steigen mit dem Alter deutlich an. Mehr zur hohen Verbreitung und den volkswirtschaftlichen Folgen kannst du auf zentrum-fuer-mobilitaet.at nachlesen.
Wie ein Schaden diagnostiziert wird
Um das genaue Ausmaß eines Knorpelschadens festzustellen, sind bildgebende Verfahren unerlässlich. Erste Hinweise kann ein Arzt oft schon durch Abtasten und Bewegungstests gewinnen, doch erst ein Röntgenbild gibt wirklich Aufschluss über den Zustand des Gelenks. Hier schaut man sich vor allem den Gelenkspalt an – je schmaler er ist, desto weiter ist der Knorpel bereits abgenutzt. In unserem Artikel über das Röntgenbild bei Hüftarthrose zeigen wir dir, wie so ein Befund konkret aussieht.
Für eine noch detailliertere Darstellung der Knorpeloberfläche selbst kommt dann oft eine Magnetresonanztomographie (MRT) zum Einsatz.
Wie Sie Ihren Knorpel aktiv schützen und stärken

Nachdem wir uns angeschaut haben, wie Knorpelschäden entstehen, kommt jetzt der Teil, auf den alle gewartet haben: die gute Nachricht. Sie sind dem Ganzen nicht hilflos ausgeliefert. Ganz im Gegenteil. Mit einem bewussten Lebensstil können Sie eine Menge tun, um Ihr Knorpelgewebe aktiv zu schützen und es langfristig stark und widerstandsfähig zu halten.
Es geht nicht darum, Ihr Leben komplett auf den Kopf zu stellen. Es geht darum, an den richtigen Stellschrauben zu drehen.
Im Grunde sind es drei Säulen, auf denen eine proaktive Gelenkpflege aufbaut: Bewegung, Ernährung und Gewichtskontrolle. Jede einzelne von ihnen ist entscheidend, um den Knorpelstoffwechsel anzukurbeln und schädliche Belastungen auf ein Minimum zu reduzieren.
Bewegung, die die Gelenke nährt
Bewegung ist der absolute Dreh- und Angelpunkt für gesunden Knorpel. Wir wissen ja jetzt, dass der Knorpel sich nur durch den Wechsel von Be- und Entlastung „ernährt“. Aber Achtung: Nicht jede Bewegung ist gleich gut. Sportarten mit harten Stößen und abrupten Stopps, wie Squash oder bestimmte Ballsportarten, können für die Gelenke schnell zu viel des Guten sein.
Ideal sind daher gelenkschonende Aktivitäten. Alles, was einen gleichmäßigen, rhythmischen Bewegungsablauf hat, ist perfekt. Solche Sportarten versorgen den Knorpel optimal mit Nährstoffen, ohne ihn zu überlasten.
Hier sind die Top-Sportarten für Ihre Gelenke:
- Schwimmen und Wassergymnastik: Im Wasser wiegt Ihr Körper nur noch einen Bruchteil. Das ist die ultimative Entlastung für die Gelenke.
- Radfahren: Die runde, gleichmäßige Tretbewegung ist wie eine sanfte Massage für den Knorpel in Hüfte und Knien. Besser geht’s kaum.
- Nordic Walking: Durch den Einsatz der Stöcke wird die Belastung auf die Knie- und Hüftgelenke im Vergleich zum normalen Gehen spürbar reduziert.
Das ist auch keine reine Theorie, sondern wissenschaftlich bestens belegt. Untersuchungen der Deutschen Sporthochschule Köln zeigen ganz klar, dass das gefäßfreie Knorpelgewebe zwingend auf regelmäßige Bewegung angewiesen ist, um den Stoffaustausch sicherzustellen. Eine Über- oder Unterbelastung kann diesen empfindlichen Prozess stören und zu Abbauprozessen führen, die am Ende in einer Arthrose münden. Wenn Sie tiefer einsteigen wollen, finden Sie mehr über die Forschungsergebnisse zur Knorpelgesundheit auf dshs-koeln.de.
Die richtige Ernährung für den Knorpel
Direkt nach der Bewegung kommt Ihre Ernährung ins Spiel. Auch sie spielt eine entscheidende Rolle. Eine ausgewogene, entzündungshemmende Kost kann helfen, chronische Entzündungsprozesse im Körper zu reduzieren, die auch den Gelenkknorpel angreifen können.
Stellen Sie sich Ihren Körper wie ein Haus vor: Was Sie als Baumaterial liefern, bestimmt, wie stabil es am Ende ist. Eine nährstoffreiche Ernährung liefert dem Knorpel genau die Bausteine, die er für seine Instandhaltung braucht.
Achten Sie besonders auf eine ausreichende Zufuhr von Omega-3-Fettsäuren (zum Beispiel in fettem Fisch wie Lachs), Antioxidantien (in buntem Obst und Gemüse) und Vitamin C. Letzteres ist für die Kollagenbildung unerlässlich.
Gewichtskontrolle zur Entlastung
Dieser Punkt ist reine Physik: Jedes Kilo zu viel auf den Rippen vervielfacht die Last auf Ihren tragenden Gelenken wie Hüfte und Knie.
Schon eine Gewichtsreduktion von nur fünf Kilogramm kann das Risiko für die Entwicklung einer Kniearthrose halbieren. Ein gesundes Körpergewicht zu halten oder zu erreichen, ist somit eine der effektivsten Maßnahmen überhaupt, um den mechanischen Druck auf den Knorpel zu verringern und ihn vor vorzeitigem Verschleiß zu schützen.
Ein paar Antworten auf häufig gestellte Fragen
Zum Abschluss wollen wir noch ein paar der häufigsten Fragen klären, die uns im Zusammenhang mit Knorpel immer wieder erreichen. Diese kurzen und knackigen Antworten sollen dir helfen, die wichtigsten Punkte zur Knorpelgesundheit noch besser zu verstehen.
Kann sich Knorpel von selbst regenerieren?
Das ist wohl die wichtigste und gleichzeitig ernüchterndste Frage. Die kurze Antwort lautet leider: kaum bis gar nicht. Stell dir vor, Knorpelgewebe ist wie eine abgelegene Berghütte ohne eigene Zufahrtsstraße. Da es keine eigenen Blutgefäße hat, fehlt der direkte Anschluss an die „Versorgungs-Lkw“ des Körpers, die Nährstoffe und Reparaturmaterialien anliefern.
Kleinere, oberflächliche Kratzer kann der Körper manchmal noch irgendwie ausgleichen. Aber bei tieferen Rissen oder großflächigem Verschleiß sind die Selbstheilungskräfte extrem begrenzt. Einmal verlorener Knorpel wächst in der Regel nicht von allein nach. Genau deshalb ist es so unglaublich wichtig, gut auf den Knorpel aufzupassen, den man hat.
Wie groß ist der Einfluss der Ernährung wirklich?
Riesig, auch wenn es ein indirekter Einfluss ist. Du kannst Knorpel nicht direkt „füttern“, denn seine Nahrung bekommt er ja über die Gelenkflüssigkeit. Aber was du isst, bestimmt die Qualität dieser Flüssigkeit und wie stark die Entzündungsneigung in deinem gesamten Körper ist.
Eine antientzündliche Ernährung, reich an Omega-3-Fettsäuren (wie in fettem Fisch), Antioxidantien (aus buntem Gemüse und Beeren) und Vitamin C (ein Muss für die Kollagenbildung), schafft ein knorpelfreundliches Klima. Gleichzeitig hilft eine ausgewogene Ernährung dabei, dein Körpergewicht im Griff zu behalten – und das reduziert den mechanischen Druck auf die Gelenke. Das allein ist schon ein gewaltiger Faktor für die Langlebigkeit deines Knorpels.
Knorpel und Knochen sind zwar ein Team, aber grundverschieden. Während Knochen gut durchblutet sind und sich ein Leben lang erneuern, ist Knorpel eher ein passives Stützgewebe ohne Durchblutung und mit einem sehr, sehr langsamen Stoffwechsel.
Welche Sportarten sind bei Knorpelproblemen geeignet?
Wenn schon ein Knorpelschaden oder eine beginnende Arthrose da ist, kommt es auf die richtige Bewegung an. Das Ziel ist klar: den Knorpel sanft „durchkneten“ und ernähren, ohne ihn durch harte Stöße weiter zu belasten.
Ideal sind daher Sportarten mit gleichmäßigen, fließenden Bewegungen, die die Gelenke schonen. Hier sind die Top-Favoriten:
- Radfahren: Die runde, gleichmäßige Tretbewegung ist einfach perfekt, um das Gelenk ohne jegliche Stoßbelastung zu mobilisieren.
- Schwimmen oder Aquajogging: Im Wasser fühlt sich der Körper fast schwerelos an. Das ist die maximale Entlastung, die du deinen Knien und Hüften gönnen kannst.
- Nordic Walking: Durch den Einsatz der Stöcke wird die Last auf die Gelenke im Vergleich zum normalen Gehen deutlich abgefedert.
Einen Bogen machen solltest du hingegen um Sportarten mit abrupten Stopps, schnellen Richtungswechseln und Sprüngen. Dazu gehören zum Beispiel Squash, Fußball oder intensives Joggen auf Asphalt. Der Schlüssel ist regelmäßige, sanfte Bewegung – sie hilft, die Gelenkfunktion so lange wie möglich zu erhalten.
Möchtest du die faszinierende Struktur des menschlichen Körpers nicht nur verstehen, sondern auch sehen? Bei Animus Medicus verwandeln wir komplexe anatomische Strukturen in ästhetische Kunstwerke. Entdecke unsere hochwertigen Vintage-Anatomie-Poster und bringe die Schönheit der Wissenschaft in deine Räume.
Entdecke jetzt unsere Anatomie-Kunstwerke auf animus-medicus.de







